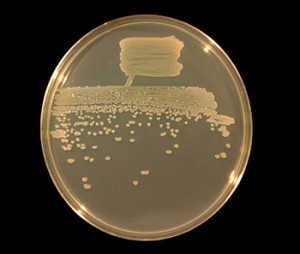
Pseudomonas

La diversidad microbiana del suelo está dada por el gran número de microorganismos que lo habitan. Los principales grupos microbianos que se encuentran en el son: hongos, bacterias, protozoos, algas y virus, estos últimos principalmente representados por los fagos.
Los hongos representan la diversidad morfológica en tanto que las bacterias representan la diversidad metabólica.
Las algas son similares a las que se encuentran en el agua, sin embargo en este ambiente pueden mostrar morfologías aberrantes.
Importancia de la diversidad microbiana en el suelo
El suelo representa un hábitat favorable para los microorganismos, entre los que se incluyen algas, hongos, actinomicetos y bacterias. Estos microorganismos, junto a los componentes de la microfauna, forman la llamada microbiota del suelo. La actividad y diversidad de la microbiota condiciona la fertilidad del suelo, la estabilidad y funcionamiento de ecosistemas naturales y los agroecosistemas. La diversidad microbiana es esencial para garantizar los ciclos de los nutrientes y los procesos de descomposición del material vegetal en cualquier ecosistema terrestre debido a los procesos biológicos como la oxidación, la reducción, la descomposición de materia orgánica y la mineralización, así como las interacciones interespecíficas e intraespecíficas que se establecen en el suelo.
La población encontrada está entre uno y 100 millones de microorganismos presentes por gramo de suelo, siendo las bacterias y hongos los predominantes, generando relaciones beneficiosas entre la diversidad microbiana, el funcionamiento de los suelos, la calidad de las plantas y la sostenibilidad de los ecosistemas. Por lo tanto, el funcionamiento de los ecosistemas es gobernado por la dinámica microbiana, la cual está influida directamente por los parámetros físicos y químicos del suelo.
En el Laboratorio de Microbiología de Suelos de la BUAP se está trabajando en estudios de la diversidad microbiológica en los suelos mediante dos líneas de investigación: la primera es referente a la fertilización biológica y la segunda corresponde a la biotecnología ambiental y agrícola. Se ha generado, a lo largo de 30 años de investigación, un banco de microorganismos provenientes de suelos asociados a plantas, donde se encuentran especies de importancia agrícola como Rhizobium, Azospirillum y Pseudomonas, entre otras bacterias fijadoras de nitrógeno, solubilizadoras de fosfatos y productoras de sustancias estimuladoras del crecimiento vegetal.
El cambio del uso del suelo, los desastres naturales, el crecimiento urbano, la contaminación por residuos químicos, la presencia de especies invasoras, las prácticas agrícolas y el cambio climático, han ocasionado amenazas a la diversidad microbiana del suelo, por lo que es importante incentivar y promover proyectos que ayuden a la conservación biológica del suelo mediante el desarrollo de alternativas biológicas, como lo son los inoculantes microbianos, cuya aplicación agrícola y forestal ha sido demostrada por el grupo de trabajo.
A partir de muestras de suelo y planta se cuantifican y aíslan bacterias y hongos de las diferentes regiones del estado de Puebla y otros estados del país. Los resultados obtenidos a la fecha han permitido realizar un diagnóstico de la diversidad microbiana. Por otro lado, se trabaja en el desarrollo de inoculantes microbianos de aplicación agrícola y forestal de las regiones estudiadas, lo que ayuda a rescatar, conservar y aumentar los rendimientos y las plantaciones agrícolas y forestales en campo. Se obtienen aislados bacterianos de diferentes regiones y de las plantas estudiadas y se les cuantifica la actividad de la nitrogenasa (fijación de N2), su efecto en la solubilización de fosfatos, la producción de sustancias antibióticas y la producción de reguladores del crecimiento vegetal. Se evalúa la respuesta en plantas de los inoculantes bacterianos desarrollados en condiciones de invernadero y campo con la selección los tratamientos con mejores rendimientos para su aplicación extensiva en cultivos agrícolas y forestales en las diferentes regiones del estado. Además, se analiza y cuantifica el contenido de contaminantes del suelo como plaguicidas, metales pesados e hidrocarburos con respecto a la normatividad mexicana vigente en las muestras de suelo de la diferentes regiones del estado de Puebla, logrando conocer el impacto de contaminantes en las poblaciones microbianas de los suelos de estudio.
se llama edafón a la biotaespecífica del suelo. La palabra aplica al suelo (edaphos) el modelo de la palabra plancton. La parte fundamental del edafon consiste en microorganismos procarióticos, hongos y pequeños animales. Por su actividad biológica el suelo alcanza muchos de los rasgos de su composición e incluso de su estructura; y por la actividad metabólica del edafon el suelo es la sede de procesos fundamentales para los ciclos de los elementos, que los mantienen a disposición de la vida.
Es posible diferenciar entre edafoflora, formada por componentes vegetales del edafon, y una edafofauna, formada por los organismos “animales”. Tal distinción es útil en la medida en que lo es la distinción entre vegetales y animales, ampliamente superada en el estudio de la diversidad biológica.
Hábitats
En el suelo existen compartimentos biológicamente diferenciados, en relación con los fluidos intersticiales y en función de la profundidad. La mayor parte de la actividad biológica se concentra en el horizonte superficial, especialmente la hojarasca. Ésta representa la transición con medios externos al suelo pero relacionados, como los troncos muertos y las galerías de insectos, que a menudo comparten algunas de las mismas especies. Las capas superficiales están sometidas a diferencias de temperatura especialmente marcadas, sobre todo en ecosistemas con poca cobertura vegetal, mientras los niveles inferiores presentan por el contrario una gran estabilidad térmica que hace, por ejemplo, que la temperatura otoñal pueda ser mayor en niveles profundos que en otros más superficiales.
La distinción principal es entre agua del suelo, adherida a las partículas, en la que habitan microorganismos procarióticos (bacterias y arqueas) y eucarióticos (principalmente protistas). El aire del suelo presenta una composición especial, pobre en O2 y enriquecida en CO2, por la falta de luz y de fotosíntesis en cuanto bajamos de la superficie mientras se mantiene la actividad aerobia. En el aire del suelo habitan animales de grupos adaptados a la respiración aérea, principalmente artrópodos.
Edafoflora
De la edafoflora forman parte las bacterias y arqueas, los hongos verdaderos, y aquellos protistas de nutrición osmótrofa (por absorción), la mayoría de los cuales han sido históricamente confundidos con hongos. En la capa más superficial habita un cierto número de protistas fotosintetizadores y de cianobacterias. También contribuyen a la vida del suelo las plantas con sus partes de la edafoflora.
Bacterias
Las bacterias (reino Bacteria) de los suelos son descomponedoras o quimiosintetizadoras. Las descomponedoras son generalmente aerobias o microaerofílicas, aunque algunas aprovechan la abundancia local de sustancias minerales oxidantes para practicar la respiración anaerobia. Un grupo de bacterias especialmente importante en los suelos son los actinomicetes, responsables del olor a tierra tan patente después de la lluvia.
Las arqueas tiene una importante presencia en los suelos. Han sido detectadas, como en la mayoría de los ambientes, por técnicas modernas de amplificación genética (semejantes a las aplicadas a la identificación en medicina forense), pero no han sido cultivadas ni se conoce bien sus modos de vida.
Hongos
La mayor parte de las plantas llevan hongos simbióticos, llamados micorrizas, asociados a sus raíces. Las micorrizas sirven de alimento a muchos pequeños animales del suelo. El capítulo principal entre los hongos del suelo corresponde a saprófitos, descomponedores que reciclan materia orgánica. Llegan a superar en este papel a las bacterias, sobre todo en suelos ácidos de climas fríos y húmedos. También hay patógenos y parásitos que afectan a las raíces o tallos subterráneos de las plantas. Un ejemplar de Armillaria ostoyae, que produce la podredumbre blanca de las raíces, ostenta el récord de dimensiones de un organismo, con su micelio extendiéndose en más de 8 km2 y una masa estimada de 7.000 toneladas.
Fotoautótrofos
La biota del suelo incluye poca biomasa de productores primarios, pero existen formas especializadas de fotosintetizadores incluso en los suelos de costra y desérticos. Su presencia se limita a, como mucho, los primeros centímetos del suelo. Se trata sobre todo de cianobacterias, diatomeas, como Hanztschia, xantófitas, como Vaucheria o Botrydiopsis, y líquenes incrustantes.
Edafofauna
Se han descrito varias decenas de miles de especies propias de la edafofauna, que forman familias, órdenes y aun filos enteros. En la fauna del suelo encontramos grupos muy especializados, por la particularidad de las condiciones que se dan allí, que suelen ser a la vez muy primitivos, porque gracias a la extensión y continuidad de los sistemas edáficos en ellos han sobrevivido muchos fósiles vivientes.
La mayor biomasa animal corresponde en suelos blandos y húmedos a los anélidos oligoquetos comúnmente llamados en castellano lombrices de tierra. Estos avanzan a través del suelo tragándolo y abandonando, tras digerir una parte de la materia orgánica, una mezcla íntima, neutra y porosa, de arcillas y sustancias biológicas que contribuye como ningún otro factor a la fertilidad del suelo.
Un segundo capítulo lo forman pequeños artrópodos detritívoros, entre los que destacan los ácaros, especialmente los oribátidos, los diplópodos y los colémbolos. Junto a éstos, otros dos grupos de hexápodos, los proturos y los dipluros son más o menos exclusivos del suelo. Otro grupo notable propio de la edafofauna son los tardígrados, estrechamente emparentado con los artrópodos. Algunos insectos, como los escarabajos estafilínidos, y arañas, como los licósidos habitan la superficie del suelo, escondiéndose en galerías, bajos las piedras o entre la hojarasca. Muchos escarabajos y algunas chinches pasan alguna fase de su desarrollo enterrados en el suelo.
Un caso especial es el de especies de la epifauna (de la superficie) que buscan regularmente en el suelo su refugio, como hacen muchos pequeños mamíferos, o que hibernan enterrándose. Algunos habitantes permanentes del suelo proceden de estirpes aéreas y han desarrollado recientemente las adaptaciones para ello, como ocurre con los topos y otros animales cuyo nombre frecuentemente alude a los anteriores, como los grillotopos o las ratas topo. y es el lugar donde se desarollan distintos tipos de actividades.
La geosmina, que significa en griego «aroma de la tierra», es una sustancia química producida por la bacteria Streptomyces coelicolor, también conocida como bacteria de Albert, y algunas cianobacterias, las cuales se hallan en el suelo y son perceptibles típicamente cuando la tierra se humedece; por ejemplo, cuando llueve. Algunos hongos filamentosos, como Penicillium expansum, también producen geosmina. Su fórmula es: 4,8a-dimetildecalina-4a-ol o 4,8a-dimetil-decahidronaftaleno-4a-ol.
El Streptomyces es un microorganismo importante en el campo de la medicina moderna y actual, dada la factibilidad de obtener a partir de él antibióticos, entre ellos, agentes antibacterianos muy conocidos como la tetraciclina, la eritromicina, la rifampicina o la kanamicina, antifúngicos como la nistatina, y agentes antitumorales, antihelmínticos e inmunosupresores, entre otros.
La investigación de su genoma ha permitido determinar el gen productor de su característico aroma, el cual al ser manipulado experimentalmente y suprimido de la bacteria, causaba la pérdida de la síntesis de geosmina.
Este compuesto es importante para los animales vertebrados que habitan el desierto, principalmente para los camélidos, quienes al percibir su olor pueden tener la seguridad de que encontraran agua en poco tiempo. Los nematodos y los insectos también se benefician de este compuesto, pues al captarlo se dirigen hacia donde se halla la humedad. Los botánicos también han descubierto geosmina en flores de cactus y flores del Amazonas, cuyos olores atraen a los insectos en busca de agua y de esta manera y accidentalmente polinizan la flor.

No hay comentarios:
Publicar un comentario